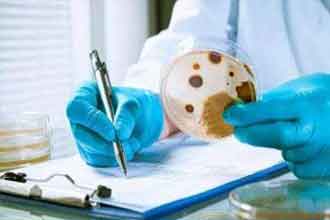
未标题-1.jpg

|
噬菌体疗法或成对抗超级细菌利器科技日报 2019-05-14 作者:冯卫东 |
据最新一期《自然·医学》报道,美英两国联合医疗团队利用3种基因改造病毒(噬菌体)组成的鸡尾酒疗法,将一名患有抗生素耐药性感染的英国少女从死亡边缘拉了回来。
现年17岁的英国少女伊莎贝尔·霍萨威患有囊性纤维化遗传疾病。至2017年夏天,其肺部功能仅剩下正常人的三分之一。在接受肺部移植手术后,差点死于顽固性感染。在英国大奥蒙德街医院治疗9个月依然不见好转后,医生认为其术后生存率不足1%。医生联系了美国匹兹堡大学霍华德休斯医学研究所的分子遗传学家格雷厄姆·哈特富尔教授。他们合作开发出一种使用3种噬菌体的鸡尾酒疗法,最终使伊莎贝尔奇迹般地康复,并重返学校。
鸡尾酒疗法使用的这些噬菌体是专门用于攻击和杀死细菌的病毒。科学家从匹兹堡大学保存的超过15000个库存噬菌体中选出3个特定噬菌体,并对其中两个进行了基因工程改造,使其能更好地攻击细菌。
2018年6月,在经过安全性测试后,研究团队开始每天两次将噬箘体混合物注射入伊莎贝尔的血液中并涂抹在她的皮肤上。治疗取得了令人难以置信的成功,6周后,伊莎贝尔的肝脏扫描显示感染基本消失,皮肤溃烂病变也大幅消除。目前,她的治疗团队正计划添加第4个噬菌体以试图完全清除她的感染。
值得注意的是,转基因病毒治疗对伊莎贝尔几乎没有产生副作用。哈特富尔教授表示:“我们没想到能将这些噬菌体用于实际的治疗之中,这是一个很好的结果。” 由于伊莎贝尔的个性化治疗方案不是临床试验的一部分,因此目前还无法得知此类治疗对其他人的治疗效果如何。毕竟,要为每位患者找到合适特定的噬菌体是一项巨大的挑战。
在未来,科学家们希望有可能对噬菌体库进行自动搜索,以识别和确定个性化治疗方案。一些感染菌株,如聚集在医院的超级细菌——金黄色葡萄球菌,由于所有该类细菌在基因上十分相似,或许只需确定一些噬菌体就能治疗几乎所有的案例,从而提高了噬菌体治疗成为常规治疗手段的前景。(冯卫东)
责任编辑:杨茗
下一篇:我科学家首次分离出小梁网干细胞
 科普中国APP
科普中国APP
 科普中国微信
科普中国微信
 科普中国微博
科普中国微博

最新文章
-
为何太阳系所有行星都在同一平面上旋转?
新浪科技 2021-09-29
-
我国学者揭示早期宇宙星际间重元素起源之谜
中国科学报 2021-09-29
-
比“胖五”更能扛!我国新一代载人运载火箭要来了
科技日报 2021-09-29
-
5G演进已开始,6G研究正进行
光明日报 2021-09-28
-
“早期暗能量”或让宇宙年轻10亿岁
科技日报 2021-09-28
-
5G、大数据、人工智能,看看现代交通的创新元素
新华网 2021-09-28













